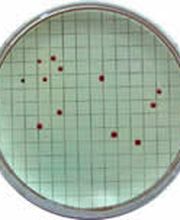
kf1.jpg

Tratamiento plagas, carcoma, termitas. legionela.
Abiomed Higiene - Control de Plagas
Laboratorio
0.0(0 Reseñas)
Calle Tercera, 28, POL. IND. EL MONTALVO III, 37188 Carbajosa de la Sagrada
+34923193727 (Teléfono)
+34923194280 (Fax)
Noticias y Ofertas
Información
Tratamiento garantizados de plagas. Protección contra carcoma y termitas. Legionela, palomas, gorgojos, etc. Laboratorio alimentario y de aguas, consultoría alimentaria.
Marcas
Bayer
Bayer
Servicios
Presupuesto sin compromiso
Presupuesto sin compromiso
Horario de apertura
- Lunes
- 09:00 a 13:30 - 16:00 a 20:00
- Martes
- 09:00 a 13:30 - 16:00 a 20:00
- Miércoles
- 09:00 a 13:30 - 16:00 a 20:00
- Jueves
- 09:00 a 13:30 - 16:00 a 20:00
- Viernes
- 09:00 a 13:30 - 16:00 a 20:00
- Sábado
- 10:00 a 13:00
- Domingo
- Cerrado
Industrias / Especializaciones
LaboratorioMedios

Mapa
Calle Tercera, 28, POL. IND. EL MONTALVO III, 37188 Carbajosa de la Sagrada
Reseñas
Reseñas no verificadas0.0
(0 Reseñas)


